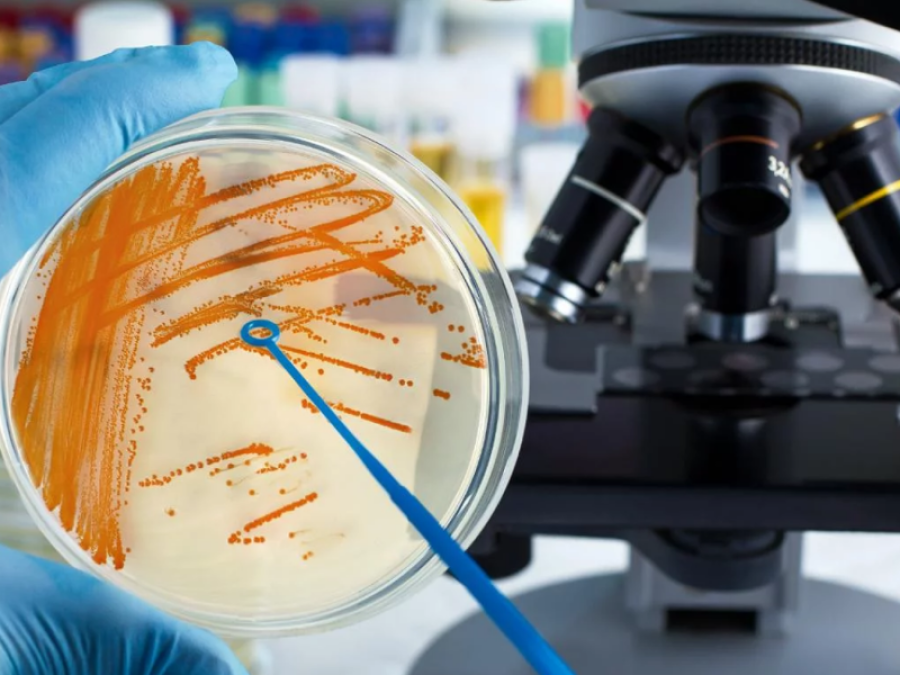
Murió en Pergamino otra persona por la bacteria estreptococo

A los cuatro casos fatales que produjo la bacteria Streptococcus pyogene -o estreptococo-, este miércoles se sumó una muerte más: un adulto falleció en Pergamino y de esta forma ya son cinco las víctimas de la enfermedad.
Las autoridades de la Región Sanitaria Cuarta confirmaron que el paciente, Nicolás Dominé, de 38 años, murió el lunes como consecuencia de la bacteria, aunque el episodio se conoció hoy. Según medios locales, había visitado a su médico de confianza por una angina, uno de los síntomas más comunes para detectar la presencia de la bacteria.

Los dos primeros casos se registraron en la ciudad de Buenos Aires, por lo que el Ministerio de Salud porteño había emitido una alerta epidemiológica. Los chicos fallecieron en el Hospital de Niños Pedro de Elizalde, en el barrio de Barracas, aunque este martes se sumaron dos muertes más: una nena de Rosario y otra de Misiones.
Liliana Benegas, directora de Epidemiología de la provincia de Santa Fe, indicó que fue un caso de septisemia generaliza y afirmó que el área de Salud Pública está en alerta. "Se le dio tratamiento, pero la evolución de la bacteria fue muy rápida y se produjo un shock séptico y no respondió", indicó.
En Posadas, Misiones, una nena de 7 años murió el sábado en el sanatorio Caminos tras ser afectada por la bacteria. Liliana Arce, jefa de Infectología del Hospital Pediátrico, señaló que, además del caso de Luana Martina Kruka, se registraron otros cinco pacientes pediátricos con ese cuadro.
Por su parte, Ivan Insúa, jefe de Epidemiología de la provincia de Buenos Aires, intentó aportar calma a la situación. "No estamos ante un brote, no hay que tener alarma. Solo algunas de las infecciones tienen un desenlace fatal", expresó.


















